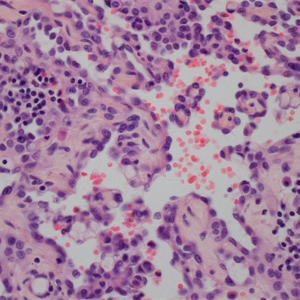
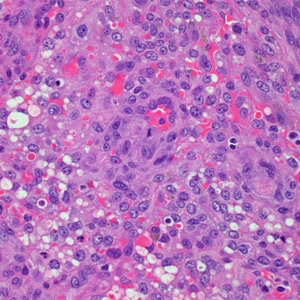

血管肉瘤
Angiosarcoma
同义词(或曾用名): 淋巴管肉瘤,血管肉瘤,恶性血管内皮瘤
概述:
软组织血管肉瘤是一种恶性肿瘤,肿瘤细胞在一定程度上具有正常内皮细胞的形态和功能特点。
发病部位: 罕见,多位于下肢深层肌肉内;
诊断要点:
罕见,多位于下肢深层肌肉内;
多结节性出血性肿物,细胞形态从梭形至上皮样不等;
上皮样区由大圆形细胞构成,细胞核分级相对高,细胞排列成片、小巢、条索或原始血管结构。
肿瘤性血管形态不规则,通过血窦结构互相连通,并破坏浸润周围组织,有些区域血管的肿瘤性内皮细胞过多,形成出芽、突起或乳头;
肿瘤细胞异型性明显,恶性程度高,核分裂象易见,瘤组织具有显著侵袭性;

免疫组织化学染色:
CD31. CD34. FLI-1. ERG(+);约 1/3 病例表达细胞角蛋白,无 INI-1 表达缺失。
鉴别诊断:
低分化癌 :发生在软组织深部少见,一般是转移性;免疫组化表达多个上皮源性标志物,不表达 CD31 和 CD34;
Kaposi 肉瘤:肿瘤主要由网状或裂隙状的毛细血管及其周围纵横交错的嗜酸性梭形细胞组成。梭形细胞间可见红细胞和透明小体。间质见淋巴细胞、浆细胞及含铁血黄素等。
上皮样肉瘤:罕见原始血管腔隙形成,瘤细胞表达 CD34 而不表达 CD31,90%以上显示特征性的 INI-1 表达缺失。
预后:
预后差。5 年总体生存率 30%-40%。影像预后特征的临床病理特征包括患者年纪,肿瘤大小,部位,深度,生长范围以及切缘状态等。提示预后不良的特征包括:患者年龄> 50 岁,位于头颈部者,多灶发生,肿瘤大于 5cm,深部体腔部位,切缘阳性,存在上皮样组织学特征和肿瘤性坏死等。
治疗:
手术切除并保证阴性切缘,完整切除困难者可采用术后放疗。
参考文献:
Meis-KindblomJM, Kindblom LG. Angiosarcoma of soft tissue: a study of 80 cases. Am J Surg Pathol 1998;22:683–697. Lahat G, DhukaAR, HalleviH, et al. Angiosarcoma: clinical and molecular insights. Ann Surg 2010;251:1098–1106.
